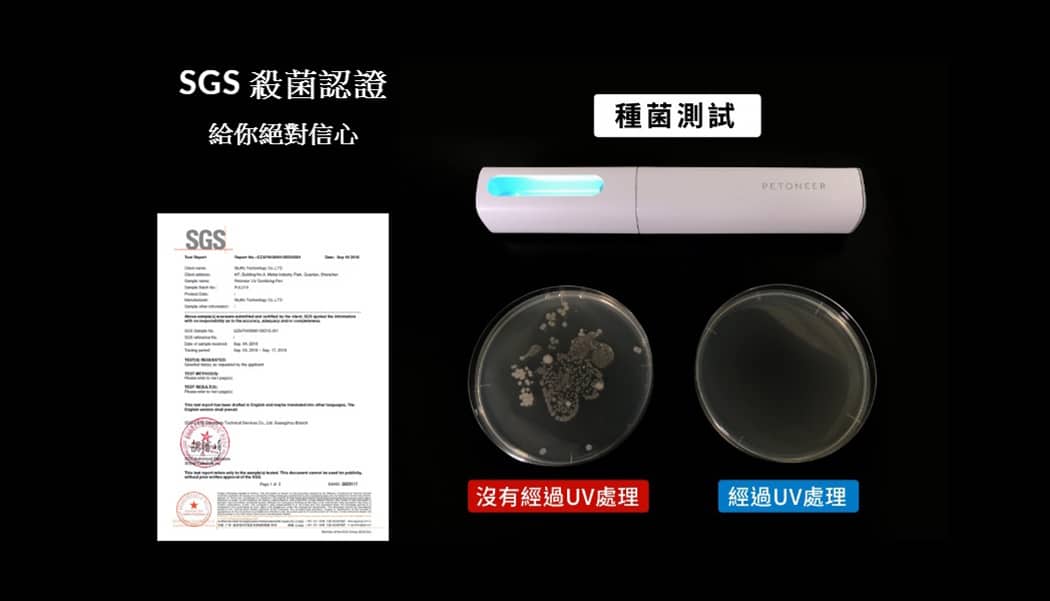

- 紫外高效殺菌,殺菌率 99%。選用 253.7nm 波長 UV-C 紫外線,直接攻擊細菌的 DNA,使其喪失繁殖能力並被摧毀,達到殺滅細菌,病毒,黴菌和其他病原體效果。即使是對化學消毒劑具有極強抵抗力的寄生蟲,如隱孢子蟲或賈第蟲,也能有效減少
- 百變“身份”應對更多場景。多用途,可放置在寵物飲水機中對寵物飲水進行攪拌滅菌,也可手持對寵物用品進行移動殺菌,百搭場景隨你使用
- SGS 殺菌認證,給你絕對信心
- 兩種模式,一鍵操控讓你使用無憂。尾部採用上萬次按壓壽命的微動開關,只需單擊便可切換 90 秒、60 分鐘兩種模式,滿足多種殺菌時長需求
- 冷陰極紫外技術,可靠持久。採用最新的冷陰極紫外技術,紫外燈壽命可達 15000 小時,擁有普通紫外無可比擬的可靠與持久
- MICRO USB 充電設計。大容量鋰電池,更方便。使用 2200mAh 鋰電池,支持 150 分鐘超長殺菌。採用 Micro USB 接口,同時支持移動電源充電,讓你隨時隨地都能擁有充沛電量
- 一體化簡潔機身,IPX7 防水,兼具美觀與功能。選用高強度聚丙烯腈材質,配合一體化工藝,讓機身不同部位 “密封” 聯接。白色圓潤的方形筆身,增加外觀質感同時,防止滾動摔落
- 材質:ABS
- 尺寸:196mm X 29mm X 30mm
- 重量:137g
- 電池種類:鋰電池
- 容量:2200mAh
- 使用時長:2.5 小時 (滿電下)
- 輸入電壓:DC 5V
- 輸入電流:800mA~1000mA (恆流時)
- 電源接口:Micro USB
- 工作電壓:DC 3.4V~4.2V
- 工作電流:<800mA
- 低電壓保護:電池電壓 ≤3.4V±0.1V
- 工作溫度:25℃
- 儲存溫度:0℃ ~ 40℃

| 重量 | 0.5 公斤 |
|---|































商品評價
目前沒有評價。